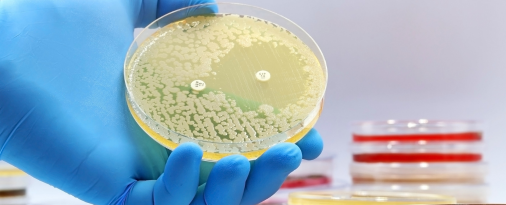

Colunista
Tudo é luta – Por Daniel Ramos

Notícias
Dia Mundial do Pulmão 2025: saiba mais sobre a campanha

Eventos
Fundadora do Unidos pela Vida participa do FAFF 2025

Medicamentos
Farmacêutica anuncia descontinuação global da tobramicina (Tobrazol®), utilizada no tratamento da fibrose cística

Medicamentos
Farmacêutica anuncia descontinuação global da tobramicina (Tobrazol®), utilizada no tratamento da fibrose cística

Eventos
Fundadora do Unidos pela Vida participa do FAFF 2025

Notícias
Dia Mundial do Pulmão 2025: saiba mais sobre a campanha
Notícias
Conhecendo as micobactérias não tuberculosas e sua relação com a fibrose cística

Eventos
Fundadora do Unidos pela Vida participa de celebração de 1 ano do Trikafta no SUS realizado pelo Hospital da Criança de Brasília

Eventos
Fundadora do Unidos pela Vida participa de audiência pública sobre acordo de compartilhamento de risco para a incorporação de tecnologias

Notícias
Registro do Trikafta na Anvisa para crianças de 2 a 5 anos: quase 2 anos de espera!

Notícias
Conheça as diferenças entre asma e Doença Pulmonar Obstrutiva Crônica (DPOC)

Notícias
O que é doença pulmonar obstrutiva crônica (DPOC)?

Medicamentos
Vertex anuncia a aprovação do Alyftrek pela Comissão Europeia




